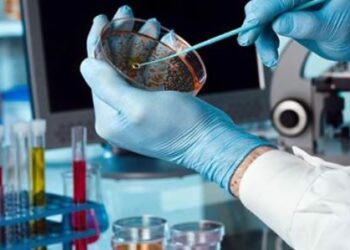

Αντίστροφη μέτρηση για τις Πανελλαδικές εξετάσεις 2019: Το πρόγραμμα, οι εισακτέοι και όλα όσα πρέπει να ξέρετε
Μία εβδομάδα έμεινε για την έναρξη των Πανελλαδικών εξετάσεων, που ξεκινούν στις 6 Ιουνίου για τους μαθητές των Επαγγελματικών Λυκείων ...